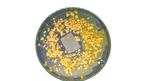
Kit d'élevage de Blob Experiment Pack !

Kit d'élevage de Blob Experiment Pack !
Le kit pour aller plus loin! Experiment Pack!
-25% SUR VOTRE COMMANDE TOUT LE MOIS DE DÉCEMBRE
Ce pack permet à tout le monde de débuter en toute simplicité et avec tout le matériel nécessaire, mais pas que! Avec ce pack, vous pourrez réveiller, faire grandir et multiplier un blob, mais aussi le voir progresser dans un labyrinthe (un labyrinthe???) tout ça à l'aide d'une loupe pour ne rien louper!
Ce pack comprend :
- Quatre sclérotes de Physarum Polysephalum
- Trois boites de pétri (9mm avec ergots)
- Une loupe (grossissement X6)
- Un labyrinthe (ajustable aux boites de pétri fournies)
- Une pipette
- Une pince
- Un sachet d'Agar-Agar
- Un sachet de flocons d'avoine
- Un guide de réveil et d'élevage
- Un sticker Blob World
Le plus de ce pack ?
Ce pack qui contient une boite de pétri en plus , une loupe et un labyrinthe vous permettra, une fois votre Blob réveillé et en forme, de le déplacer dans une nouvelle boite de pétri et de le voir évoluer pour trouver sa nourriture! Vous pourrez voir comment un Blob, malgré son manque de neurones, réussi à résoudre un problème... mieux que nous! La loupe vous permettra de voir les veines créées par celui-ci ainsi que la manière dont il enveloppe un flocon ou encore la vitesse à laquelle il cicatrise!
Qu'est ce que l'assurance Blob?
En souscrivant à l'assurance Blob, soyez sereins! Si aucune des sclérotes ne se réveille il vous suffira de nous envoyer des photos ainsi que le numéro de votre commande pour qu'on vous en renvoie! Tout le monde a droit à une seconde chance ;) Pour en savoir plus, rendez-vous sur la page Assurance Blob .
Élevez votre propre Blob avec notre kit éducatif pour enfant et adulte. Cette activité passionnante, étudiée à l'école, enseigne la démarche scientifique tout en occupant les vacances. Un cadeau original qui plaira aux jeunes et éveillera leur curiosité pour l'environnement.